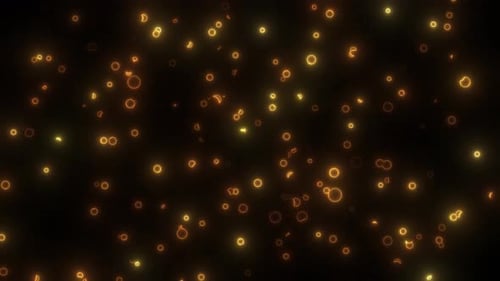
Seamless Loop of Abstract Glowing Golden Particles

Abstract Glowing Orange Particles Flowing Background
By paradox_filmsOne great value subscription from $16.50/month
- Unlimited downloads of 26+ million creative assets
- AI Tools: video, image and more
- Lifetime commercial license
- Easy cancellation
- Length
- 0:30
- Resolution
- 3840 x 2160
- File Size
- 304 MB
- Frame Rate
- 29.97 fps
- Alpha Channel
- No
- Looped
- No
- Video Encoding
- H.264
- Orientation
- Horizontal
- Commercial License
- Further Information
Description
This captivating animated background showcases a mesmerizing flow of luminous, small orange and yellow particles. Against a stark black backdrop, these glowing circles and crescent shapes dynamically move and coalesce, creating a vibrant and ever-evolving visual spectacle. The continuous stream suggests complex data transfer, a futuristic network, or a fluid energy current, making it exceptionally versatile for various digital applications. Its smooth, undulating motion and radiant glow provide a modern and sophisticated aesthetic, perfect for enhancing technology-themed presentations, digital interfaces, video intros, video overlays, or any project requiring an abstract and energetic visual layer. The subtle depth of field and consistent luminosity contribute to a polished and professional appearance. The seamless looping design ensures extended usability without interruption, adding depth and dynamism to your content, making it an excellent resource for motion design and visual effects.